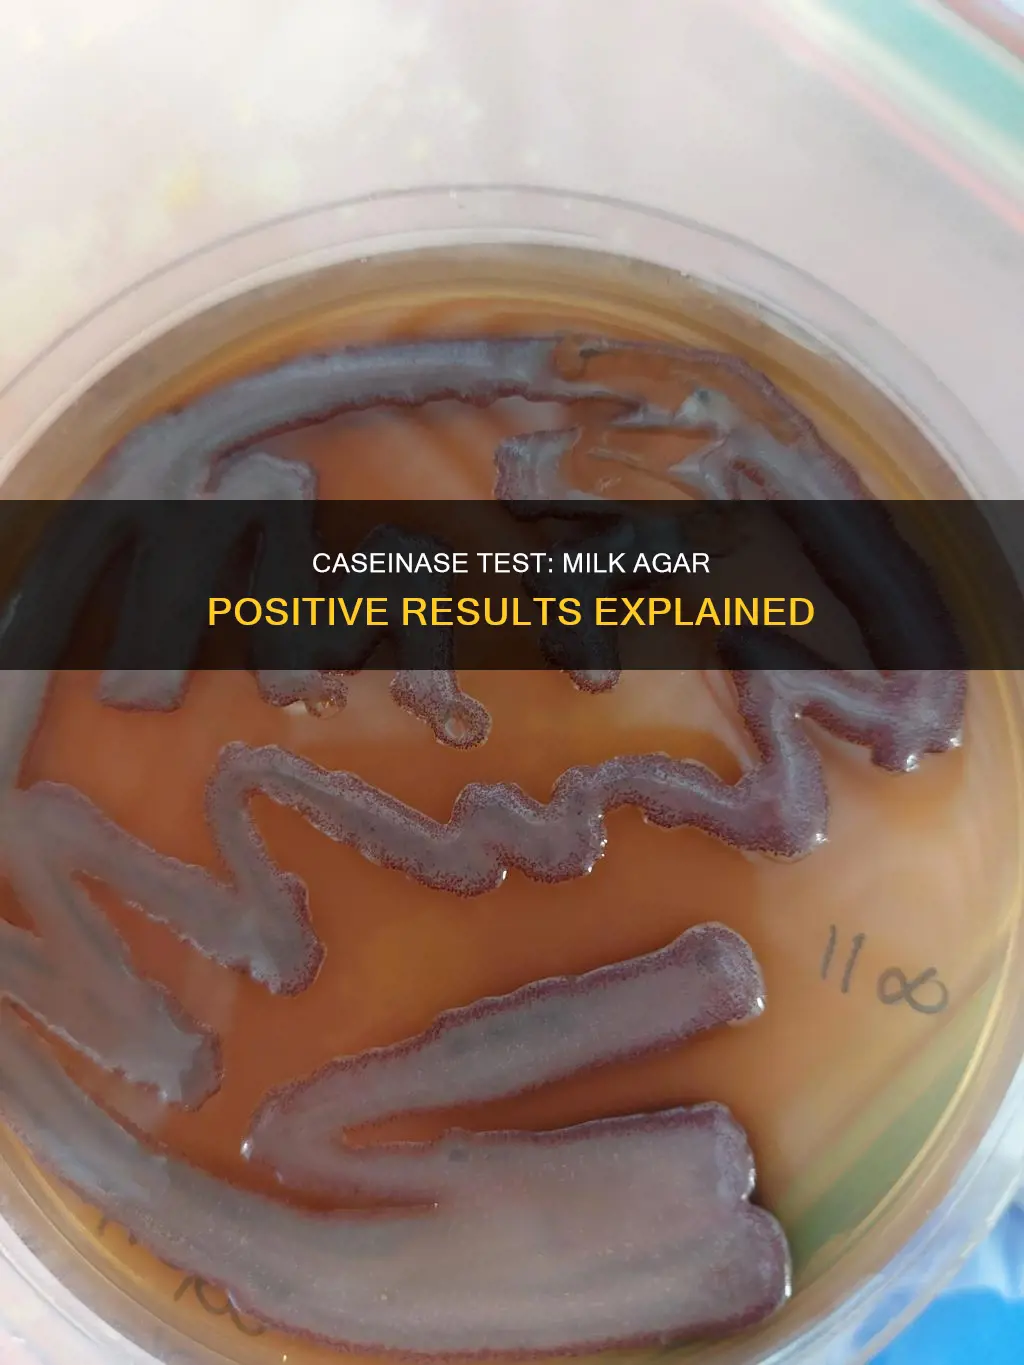
what constitutes a positive caseinase test for the milk agar

The casein hydrolysis test is a biochemical test used to determine bacteria's ability to synthesize the caseinase enzyme. Casein is the dominant milk protein, and some bacteria can produce the proteolytic exoenzyme caseinase, which breaks down casein into smaller amino acids. The test involves inoculating and incubating milk agar plates, which contain skim milk powder, tryptone, yeast extract, dextrose, and agar. A positive test result is indicated by the formation of a clear transparent zone around or beneath the bacterial colony, due to the degradation of casein protein, resulting in soluble, non-colloidal amino acids. This test helps identify microorganisms that grow in milk and differentiate between bacterial families.
| Characteristics | Values |
|---|---|
| Colour of medium | Opaque and milky white |
| Incubation temperature | 25-35°C |
| Incubation period | 14 days |
| Positive test result | Formation of a clear transparent zone of hydrolysis around the line of growth (colonies) |
| Negative test result | No zone of hydrolysis around the line of growth (colonies) |
Explore related products
What You'll Learn

The test identifies bacteria that grow in milk
The casein hydrolysis test identifies bacteria that can grow in milk. Casein is a dominant milk protein, a macromolecule made up of amino acid subunits linked by a CO-NH bond. It is responsible for the white colour of milk.
The test uses milk agar, which contains skim milk (lactose and casein), peptone, and agar. This medium is used to detect the production of proteases/caseases that digest casein. The milk agar is inoculated with the bacteria being tested, which is then incubated.
After incubation, the plates are observed for the development of a clear zone of casein hydrolysis around the line of bacterial growth. This clearing is due to the formation of soluble molecules by the degradation of casein protein, which results in a loss of opacity. This is a positive result. A negative result is indicated by no clear zone of hydrolysis around the bacterial growth.
The casein hydrolysis test is an important tool for identifying bacteria that grow in milk, as well as differentiating between different families of bacteria. It is often used to test bacteria that are of concern to or isolated from food, especially milk and dairy products.
Immunity Types: Understanding Constitutional Violation Exemptions
You may want to see also
Explore related products

Casein hydrolysis is the degradation of casein protein
The casein hydrolysis test is used to identify microorganisms based on their ability to produce the exoenzyme caseinase, which catalyses the breakdown of casein. The test involves inoculating a skim milk agar plate with a straight or zigzag line of the test organism. The plate is then incubated at a temperature between 25°C and 37°C for 18 to 24 hours. After incubation, the plate is examined for the presence of a clear zone of hydrolysis around or beneath the colonies, indicating a positive result. A negative result is indicated by the absence of a clear zone.
The casein hydrolysis test is important for identifying and differentiating microorganisms, particularly those isolated from milk and dairy products. Some common microorganisms that give a positive test result include Lactococcus lactis, Pseudomonas spp., Bacillus subtilis, and Bacillus cereus. On the other hand, Escherichia coli and Enterococcus faecalis are examples of microorganisms that yield a negative result.
Casein hydrolysis is also relevant in various industries, such as food, drug, and cosmetics, due to its functional properties and natural abundance. Enzymatic hydrolysis is often used to modify the structure of casein to enhance its functionality. The degree of hydrolysis increases rapidly during the initial stage of hydrolysis and then reaches a plateau. This process results in significant changes in molecular weight distribution and structural characteristics compared to the original casein protein.
The Constitution's Original Sin: What Was Left Out?
You may want to see also
Explore related products
$20 $44.99

The test differentiates between bacterial families
The casein hydrolysis test is a biochemical test that identifies bacteria based on their ability to produce caseinase enzymes. Casein is the dominant milk protein, a macromolecule composed of amino acid subunits linked together by a CO-NH bond. It is white and opaque in colour, and responsible for milk's whiteness.
The test involves inoculating a sample organism onto an SM agar plate, which contains casein proteins. The plate is then incubated at 25 to 35°C for 24 hours. After incubation, the plate is observed for the development of a clear zone of casein hydrolysis around the line of bacterial growth. This clear zone indicates a positive result, meaning the bacteria can produce caseinase enzymes.
Not all bacteria can synthesize caseinase, so this test differentiates between bacterial families based on their ability to produce this enzyme. Examples of bacteria that give a positive test result include Lactococcus lactis, Pseudomonas spp, Bacillus subtilis, and Serratia marcescens. On the other hand, Escherichia coli and Enterococcus faecalis do not produce caseinase and will yield a negative result.
The casein hydrolysis test is particularly useful for identifying bacteria that grow in milk and dairy products, as well as differentiating between bacterial families like Bacillaceae and Enterobacteriaceae.
Constitution Achievements: A Foundation for Freedom and Rights
You may want to see also
Explore related products

A positive test is indicated by a clear zone
The casein hydrolysis test is a biochemical test used to determine a bacterium's ability to produce the caseinase enzyme. Casein is the dominant protein in milk, giving it its white colour.
The test uses a medium of skim milk agar, which is composed of skim milk powder, tryptone, yeast extract, dextrose, and agar. This medium is opaque and milky white due to the presence of casein. After inoculating the sample organism onto the agar plate, the plate is incubated at 25 to 35°C.
Following incubation, a positive test result is indicated by the formation of a clear, transparent zone around or beneath the bacterial colony. This clearing occurs because the bacteria produce the caseinase enzyme, which hydrolyzes the casein protein into smaller, soluble amino acids. This hydrolysis breaks down the macromolecule structure of casein, resulting in the loss of opacity and the appearance of a clear zone.
Examples of microorganisms that yield positive test results include Lactococcus lactis, Pseudomonas spp., Bacillus subtilis, and Serratia marcescens. The presence of this clear zone is a definitive indicator of a positive test, demonstrating the bacteria's ability to synthesize the caseinase enzyme.
To enhance the clarity of the zone of hydrolysis, the plate can be flooded with a 10% trichloroacetate solution. Additionally, a heavy inoculum is recommended for larger zone sizes and quicker results. By following these procedures and observing the formation of a clear zone, the casein hydrolysis test effectively identifies bacteria capable of producing the caseinase enzyme.
Longer Constitutions: Benefits of a Detailed Framework
You may want to see also
Explore related products

The medium is composed of skim milk powder
The casein hydrolysis test is a biochemical test used to determine bacteria's ability to produce the caseinase enzyme and break down casein, the dominant milk protein. This test is particularly relevant for bacteria isolated from milk and dairy products.
The medium used for the test is composed of skim milk powder, which acts as the source of casein, the milk protein. Skim milk powder gives the medium its opacity and colour. Casein is a white, insoluble protein, and when it is digested by exoenzymes, the medium turns clear and colourless.
To prepare the medium, each part of the medium, except for the agar, is dissolved in 500 ml of distilled water in 1000 ml flasks. The pH of the medium is adjusted to 7.0, and then agar powder is added to bring the volume to 1000 ml. The medium is heated in an autoclave and poured into Petri dishes to set.
The test procedure involves inoculating the skim milk agar plate with the sample organism. This is done by drawing a straight or zig-zag line on the surface of the plate. The plate is then incubated at 25-35°C for 24 hours to a few days, depending on the temperature. After incubation, the plate is examined for the presence of a clear zone of hydrolysis around or beneath the bacterial growth. This clearing indicates that the bacteria have produced caseinase enzymes, which have hydrolyzed the casein, resulting in the formation of a transparent zone.
A positive caseinase test result is indicated by the presence of a clear, transparent zone around or beneath the bacterial colony growth. This clearing is due to the hydrolysis of casein, which breaks down the large casein molecules into smaller, soluble amino acids. The soluble molecules formed during hydrolysis cause the medium to become transparent.
In summary, the medium for the casein hydrolysis test is composed of skim milk powder, which provides the casein protein. The test procedure involves inoculating and incubating the skim milk agar plate, followed by observing the plate for the development of a clear zone, which indicates a positive caseinase test result.
George Mason: Champion of the Bill of Rights
You may want to see also
Frequently asked questions
The test is used to determine the ability of bacteria to synthesize the caseinase enzyme. Casein is the dominant protein in milk, and the test identifies microorganisms that can grow in milk.
A positive result is indicated by the formation of a clear, transparent zone of hydrolysis around or beneath the bacterial colony. This is due to the degradation of casein protein, resulting in soluble, non-colloidal amino acids.
A negative result is indicated by the absence of a clear zone of hydrolysis around or beneath the bacterial colony. The medium surrounding the growth of the organism remains opaque, showing no protease activity.





























































